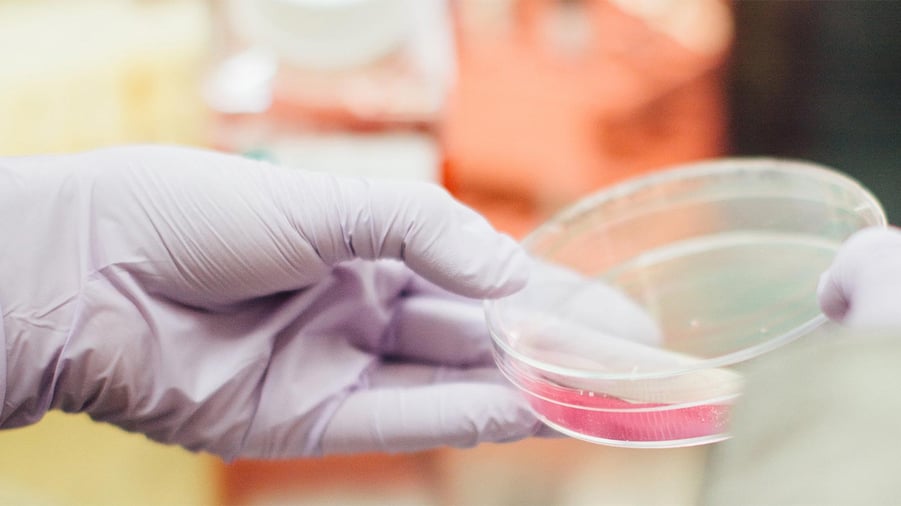
hand som håller i forskningsutrustning

Nu har regeringen överlämnat sin forsknings- och innovationspolitiska proposition. Bioekonomiområdet lyfts fram som ett viktigt spetsområde. Två viktiga satsningar i propositionen är ett nytt forsknings- och innovationsprogram med fokus på cirkulär bioekonomi, samt en tioårig forskarskola om bioekonomi.
– Ett forsknings- och innovationsprogram för bioekonomins område är en viktig satsning som kommer vara betydelsefull för att svensk skogsindustri ska kunna bibehålla och utveckla en fortsatt stark konkurrenskraft på globala marknader. Därför har vi efterlyst ett sådant program och kan nu glädjande konstatera att regeringen öronmärker medel för detta, säger Viveka Beckeman, vd för Skogsindustrierna.
Inom ramen för Formas anslagsökning för forskning avsätts 25 miljoner kronor 2025 för det nya forsknings- och innovationsprogrammet med fokus på cirkulär bioekonomi inklusive skog. Därefter beräknas 35 miljoner kronor 2026, 60 miljoner kronor 2027 och 83 miljoner kronor 2028.
En viktig fråga för framtidens biobaserade processindustri är kompetensförsörjning. Därför välkomnas den satsning på en tioårig forskarskola om bioekonomi som ursprungligen föreslogs i utredningen En hållbar bioekonomistrategi – för ett välmående och fossilfritt samhälle.
– Kompetensen behöver stärkas både inom akademin och industrin. Därför ser vi från industrins sida fram emot att få sätta igång ett antal industrinära forskningsprojekt i samverkan med akademin för att utveckla processer och kunskap, säger Torgny Persson, chef för forskning och innovation på Skogsindustrierna.
Inom ramen för Formas anslagsökning för forskning avsätts 15 miljoner kronor 2026 för en forskarskola om bioekonomi. Därefter beräknas 20 miljoner kronor 2027 och 27 miljoner kronor 2028 för detta ändamål.
Här kan du läsa hela regeringens forsknings- och innovationspolitiska proposition.